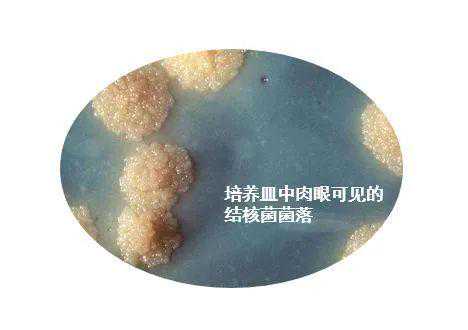

2020年3月24日是第25个世界防治结核病日(WTBD),今年我国的宣传主题是:携手抗疫防痨、守护健康呼吸。
结核病是人类历史上最难应对的传染病之一。全球每年因为结核病死亡的人数是150万,约有20亿人为结核菌携带者。中国每年新发结核病病例80万,其中1/10会出现耐药性。
看不见的敌人,看得见的数字
在我们的生活中,对生命产生威胁的事物随处可见,譬如雾霾,但另外那一部分“看不见的敌人”也让我们很容易忽略掉,直到付出惨痛代价。病菌就是“看不见的敌人”中的一员,如果我们能看见这些这些病菌,我们就会知道,除了军队,还有一支公共卫生的队伍在保护大家的安全。
首先,“看不见的敌人”是如何被“看见”的?
时针拨回到1882年,来自德国的科学家科赫(RobertKoch)提出了一个大胆的想法:所有传染病一定有致病细菌,有细菌就一定可以通过科学方法培养,而且植入到动物体内就一定可以让动物也感染相同的疾病。后来,科赫用这种办法发现了结核菌,并获得了当年的诺贝尔奖。

结核病对人类的危害,即使那些最可怕的传染病如鼠疫、霍乱也应列于其后。
——罗伯特·科赫,于19世纪
作为人类最古老的传染病,早在7万年前人类还未走出非洲的时候,结核病就已经出现了。后来,科学家们用基因测序的方式了解到,结核病像HIV、鼠疫、SARS等疾病一样,最早出现在动物身上,然后传染给人的。直到现在,依然还有人畜共患的结核病存在,比如牛结核。
一个几万年前便存在的敌人,现在看来仿佛还离我们很遥远,但并不代表着它就此偃旗息鼓、销声匿迹。
这种古老的疾病伴随着我们贯穿了历史,也无疑造成了巨大的危害,但它又是个成功的隐形敌人——在19世纪以前,人们甚至都不知道它的存在。最主要的原因是,结核菌能够狡猾地把自己隐藏起来,它不会显露出很典型的症状,还可以在除了头发以外的人体各个组织引起疾病。
它可以引起的症状或疾病包括咳嗽、脑膜炎、淋巴结肿大,也可以引起佝偻病。
现在,结核病在全球每年会带走150万人的生命,这个数字意味着地球上每分钟就会有三个人因为结核病去世。如果我们只单纯地从致病危害来考虑,那么结核病致死的人数是所有传染病当中的第一名。

发病人数还要数倍于这个数字:结核病全球每年发病人数是1000万。同时,在全球70亿人中,差不多有1/4的人体内携带着活的结核菌,一生中可能有5-10%的机会变成结核病人。
结核菌的三大技能
现在,我们来揭穿结核菌的真面目。

左滑查看多图
这些其貌不扬的结核菌有三大技能来增强它们的“威力”:
首先,结核病是一种靠空气就能传播的疾病,通过咳嗽、打喷嚏和吐痰的方式,结核病人就可以把细菌传播到空气中。考虑到当下人群密集的公共交通,控制结核病的传播就显得愈发重要。这是结核菌的第一个技能,“空降”。
进入人体后,结核菌就开始使用它的第二个技能,“潜伏”——我本人称它为“装死”。我们之前提到,结核菌是非常狡猾的,它们不会马上致病,而是要先试探一下载体的免疫抵抗力。如果遇到一个免疫力很强的人,那么结核菌就会进入休眠状态,它跟人类相处的悠长历史令它衍生出了这样的本事:只要不造成危害,免疫系统就允许它与我们共存;但是一旦宿主的免疫力降低,比如年纪大了、生病了,结核菌就会马上开始“搞事”,繁殖致病。
第三个技能,“迭代”——“没有杀死你的,只会让你变得更强大”,这句话同样适用于公共卫生和结核病防治领域。具体来说就是结核菌会产生耐药性,如果没有把结核病人治好,那么病人体内的结核菌就会通过变异产生耐药,“变得更强大”。

战胜结核病卡介苗重要但有不足
临床上有无数结核病人,也能够见到无数病情严重的孩子。目前所有中国儿童出生时都会接种两针疫苗,一针是预防乙肝的乙肝疫苗,一针是预防结核病的卡介苗。其实,卡介苗不能够预防结核病发病,但能够预防非常严重的结核病,因此卡介苗的接种对于孩子来说是非常必要的。

在疫苗暂时还没有办法消除结核病的情况下,我们只能以最快速度发现结核病人,并提供其最好的治疗方法,从而避免结核菌的传播。
在1990到2010年间,诊断只能使用显微镜检测,确诊后病人需要服用6个月国家免费提供的板式药,但是病人的症状往往在一两个月后就得到缓解,继续服药反而会出现身体发痒、肠胃不适等副作用,因此许多病人选择了停药。
上文提到结核菌的三大技能,非常可怕的技能之一就是“迭代”:一旦停药,就会形成严重耐药,需要再治疗两年,而且治愈率很低。
过去许多医生由于担心病人自行停药从而导致耐药,于是自己开展了相应的管理措施,到病人家里拜访,“送药到手,服药到口,服完再走”,在那个阶段为中国的结核病治疗起到了很好的作用。
每10年,中国都会做一个全国性的结核病流行病学调查。最近三次的调查数据显示,中国结核病的发病率不断下降,尤其是2000年到2010年,发病率降低了一半。

但是由于这10年来中国经济在飞速发展,我们也会考虑一个问题,到底是公共卫生系统的工作成效,还是经济的发展带来的改善?
调查结果显示,新病人(红色部分)没有明显减少,这是由于全球20亿的结核菌感染人群会缓慢发病。图中降得最快的是蓝色的部分,意味着已知结核病患者被治愈,而逐渐变少,这就是我们卫生系统所起到的作用。
新的挑战:耐药结核菌
一个新的挑战正在愈发艰巨——耐药结核病。现在,中国的产生了耐药性病人的数量,大约占所有结核病人的10%。
2010年,《柳叶刀》上发表了一篇文章:研究者们在印度和巴基斯坦发现了一种超级耐药菌NDM-1,对当时所有的抗生素都产生了耐药性,这个消息如同一记重磅,让所有国家都很紧张。
那么,比起超级耐药菌,耐药结核病会更厉害吗?

在致病人数方面,每年只有几百人发病NDM-1被耐药结核病完全碾压——耐药结核病每年有50万人发病。
在感染途径方面,超级耐药菌只会对免疫力特别低下的住院病人产生威胁,而我们不要忘了耐药结核病的“空降”技能,它通过空气就能传播,一个没经治疗的结核病人,一年内大约可以传染15个人。
在治疗方面,超级耐药菌虽然在被发现的时候“无药可治”,但是只要新的抗生素被研发出来,两周时间就可以把病人治好。与之相比,耐药结核病至少需要3到4种新药,而且目前而言,最短疗程是6个月,有时还会长到24个月。
所以二者的差距已不言而喻,我们一定要找到一个针对耐药结核病的更好的解决方案。
消除结核病科研是关键
结核病防治在全球共同的一个目标是2030年消除结核病。

现在全球结核病年递降率为2%,按照这个概率,100年后才能消除结核病。而在中国使用新的模型将现有工具用到最好的情况下,年递降率可以达到近10%的递降率,然而这仍然不足以完成2030年消除结核病的目标。
要在2030年消除结核病,我们需要达到17%的年递降率,需要新的工具引入,包括保证不发病的疫苗、2个月就能治好结核病的方案、更好的预防保护措施等。

现在的电子药盒仍然需要病人将药盒带到医院,随着科技技术创新,未来将可能通过无线传输使医生得以随时了解病人的服药情况;
新一代的分子诊断工具预计在今年年底或明年年初上市,为及时诊断作出巨大贡献;
盖茨基金会和北京市政府、清华大学共同成立了国内第一家非盈利的全球健康药物研发中心,积极研发结核、疟疾等公共卫生药物,明年将有一个结核病药品进入临床实验。
我们期望在未来的5到8年,能有更好的诊断工具、药物,甚至疫苗,不仅是在中国消灭结核病,也在全球消灭结核病!(终)

倡导健康生活
ID:lpsswsjsw
主办:六盘水市卫生健康局
地址:六盘水市钟山区黄土坡康乐北路2号
电话:传真:






